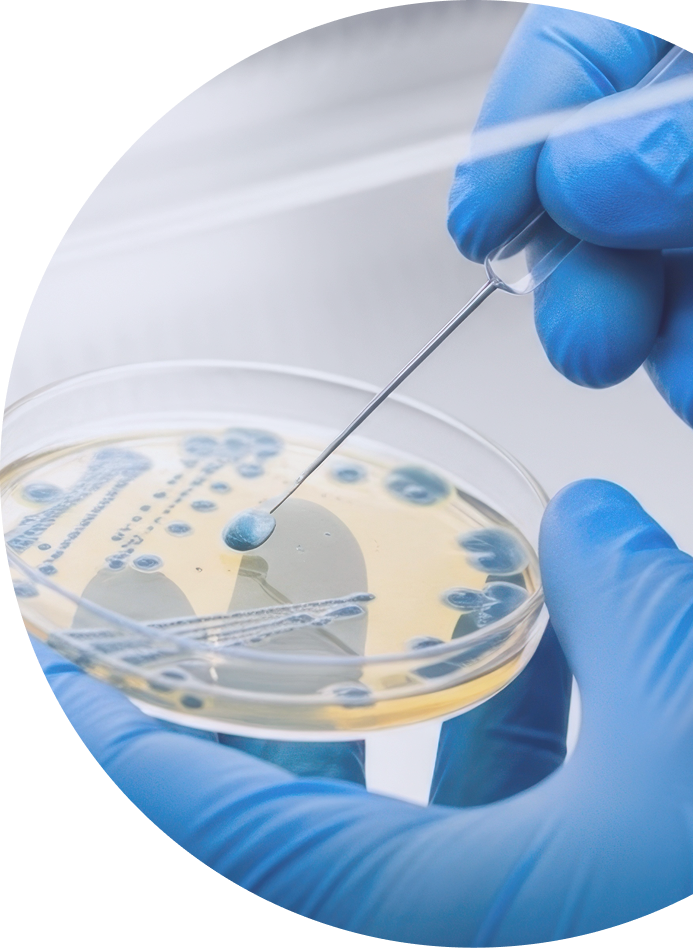

We are a multi-disciplinary team working on drug-resistant infections
Led by Professor Catrin Moore and based at City St George’s, University of London, we focus primarily on the quality and sharing of data and on interventions to reduce the burden of antibiotic resistance (AMR) in common community-acquired diseases such as urinary tract infections.
Our group leads global and regional dialogues around minimising AMR, addressing the use and misuse of antibiotics globally and other interventions especially in low- and middle-income countries.

People

Professor in Global Health and Infectious Diseases

Senior Research Project Manager

Project Manager

Honorary Clinical Lecturer

Senior Research Fellow

Postdoctoral Bioinformatician

Research Fellow

Research Fellow

PhD Student

PhD Student

Researcher
Collaborators

USA

Uganda

Uganda

France

UK

Hong Kong

UK

UK

Sweden
We are working on a number of projects. Most of these are focused on drug-resistant infections specifically relating to UTIs. These include:
Comparison of community and hospital Antibiotic use practices, Susceptibility and resisTance and determinants of care seeking among patients with Urinary Tract Infections.
This pilot study examines antibiotic resistance in acute urinary tract infections across two socioeconomically diverse Kampala neighbourhoods. The research investigates patients who visit community pharmacies and outpatient clinics, comparing local resistance patterns with WHO Uganda data whilst examining prescribing practices, patient demographics and multi-drug resistance prevalence.
Using phenotypic and genomic techniques, together with social science to understand the patient pathways for treatment. The study aims to establish a framework applicable to other low- and middle-income countries, facilitating intervention strategies to promote appropriate antibiotic use and reduce antimicrobial resistance-related mortality.

Partners: Makerere University, Infectious Disease Research Centre, BioAmp, UTI-lizer
Researchers: CSG – Prof Catrin Moore, Dr Miriam Namtamu, Dr Arun Decano.
Makerere University – Prof Henry Kajumbula (PI), Dr Freddy Kitutu. IDRC – Dr James Kapisi (PI), Social scientists: Deborah Ekusai Sebatta, Tuheirwe Honest Kabaoba, Jonathan Enomut. Pharmacists/data analysts: Nakamanya Sharon Kitibwakye, Princess Edrine Kirabo, Solomon Gobba. Microbiology staff: Nalwanga Winnie, Masengere Agnes,Peter Amanya (MSc student)
Funder: The Wellcome Trust
Outputs



The Comprehensive Understanding of Disease and AI Research project
The CURE project addresses antimicrobial resistance by creating a comprehensive global data landscape mapping clinical, microbiological and antimicrobial use information. Using novel artificial intelligence tools, the project will describe the data landscape and begin to harmonise disparate datasets by outlining a common data platform that could be used. With SmartBiotic the team are harmonising data, using AI algorithms to enhance and fill gaps in currently existing clinical microbiology data which is informing evidence-based treatment guidelines. Through systematic reviews and collaboration with international experts, CURE will develop freely available tools that establish a scalable platform for AMR data, with future expansion planned across the One Health framework to support global efforts in reducing inappropriate antibiotic prescribing.
Partners: SmartBiotic, University of Leeds
Researchers: Dr Anne-Sophie Jung, Prof Ed Alonso, Dr Fredrick Mutisya, Louis Vezard, Taïoh Yokoyama, Dr Sana Boujaafar, Dr Mathieu Raad, Prof Catrin Moore
Funder: iiCON & UKRI
This Fellowship Scheme strengthens antimicrobial resistance workforce capacity by supporting professional development of practitioners within government institutions across Fleming Fund countries. Our team of mentors in CSG and RVS mentor fellows in specialised disciplines, they are in turn training their colleagues using their newly acquired skills. The programme focuses on advanced scientific and leadership development, bringing together human, animal health and environment professionals through a One Health approach. The team are currently supporting nine fellows in Eswatini, the scheme enhances capabilities in AMR diagnostic data collection, surveillance, data management and practical application to improve national AMR response. Two of the current Fellows recently ran a workshop on microbiology quality improvement in Piggs Peak, Eswatini which was supported by this work and the British High Commission in Eswatini.
Partners: Royal Veterinary College, University of London
Beneficiary Institutions: Eswatini Ministry of Health, Department of Veterinary Services – Central Veterinary Laboratory, Hlathikhulu Government Hospital, Good Shepherd Mission Hospital, Department of Water Affairs, Ministry of Agriculture Veterinary Public Health Division Food Hygiene Laboratory, Mbabane Government Hospital Laboratory
Mentors: Prof Catrin Moore, Prof Jodi Lindsay, Dr Yingfen Hsia, Dr Kurt Arden, Dr Sian Frosini, Dr Steven van Winden, Prof Anette Loeffler, Prof Tariq Sadiq, Dr Peter Crook, Dr Lauren Hookham, Dr Richard Booth, Dr Sally Baker
Mentees:
Andiswa Tenkhosi Dlamini – AMR Laboratory – Human Health
Bongiwe Elizabeth Ngozo – AMU-C Surveillance – Animal Health
Makhosazana Shongwe (Khosi) – AMR Laboratory – Environment
Precious Mumbi Chishimba – AMU-C Surveillance – Human Health
Nelisiwe Euphene Khumalo – AMU-C Surveillance – Animal Health
Melusi Welcome Mthembu – Antimicrobial Stewardship – Human Health
Nomcebo Fortunate Zondo – Antimicrobial Stewardship – Human Health
Bavukile Siphosethu Kunene – Antimicrobial Stewardship – Animal Health
Sifundo Patience Zwane – AMR Policy – Human Health
Alumni:
Mcolisi Buyisizwe Fakudze – AMR Laboratory – Animal Health
Zizwe M. Cindzi – AMU/C – Animal Health
Ronnie Mkoko – AMR Surveillance – Human Health
Sihle Gamma – AMU/C – Human Health
Funder: Department of Health & Social Care
Website: Fleming Fund Fellowships
Prof Moore co-leads the Microbiology Society’s Knocking Out AMR project, a four-year initiative addressing the global antimicrobial resistance crisis. The project has convened 135 experts across One Health sectors to develop solutions in surveillance, diagnostics, vaccines and policy. Prof Moore led workshops in 2025 using an innovative complex systems approach. The initiative identified barriers and interventions, with findings published online. Prof Moore leads engagement activities including the AMR in Focus series, educational resources and collaboration with UK health agencies, representing the Society at high-level policy meetings including the 2024 UN General Assembly on AMR.
Website: Knocking Out Antimicrobial Resistance | Microbiology Society
Building on the ADILA initiative, the teams role in TACE is to enhance antimicrobial use data and quality across low- and middle-income countries in Africa and Asia. In partnership with IVI (Asia lead) and Fondation Mérieux (African lead), the project strengthens local surveillance and stewardship through training, technical support and through the use of data analysis tools. The TACE project promotes appropriate antibiotic prescribing using AWaRe Quality Indicators and a visualisation dashboard, enabling healthcare teams to integrate data into clinical care. The project empowers countries to address antimicrobial resistance through targeted, context-specific strategies based on local evidence.
Partners: University of Oxford, Global Point Prevalence Survey, International Vaccine Institute, Fondation Mérieux
Funder: Department of Health & Social Care
Websites: TACE AFRICA | TACE ASIA
Antibiotic Data to Inform Local Action
The project aimed to develop open-access analyses and tools to guide national and local antibiotic prescribing policies. Key objectives included developing a methodology for deriving AWaRe-based national antibiotic targets, AWaRe quality indicators, methodology for collecting antibiotic prescribing data in primary healthcare, and for estimating expected antibiotic use in hospital and primary care based on clinical burden.
Partners: University of Antwerp, University of Oxford, Liverpool School of Tropical Medicine, Mahidol Oxford Tropical Research Unit,
Cambodia Oxford Medical Research Unit, National University of Singapore, Kenya Medical Research Institute
Researchers: Profs Michael Sharland and Catrin Moore at City St George’s, University of London, Dr Koen Pouwels at Nuffield Department of Primary Care Health Science and Dr Ben Cooper at Centre for Tropical Medicine and Global Health at the University of Oxford
Funders: The Wellcome Trust
Website: Antibiotic Policy Group – ADILA
Browse projects
CAST-UTI
Comparison of community and hospital Antibiotic use practices, Susceptibility and resisTance and determinants of care seeking among patients with Urinary Tract Infections.
This pilot study examines antibiotic resistance in acute urinary tract infections across two socioeconomically diverse Kampala neighbourhoods. The research investigates patients who visit community pharmacies and outpatient clinics, comparing local resistance patterns with WHO Uganda data whilst examining prescribing practices, patient demographics and multi-drug resistance prevalence.
Using phenotypic and genomic techniques, together with social science to understand the patient pathways for treatment. The study aims to establish a framework applicable to other low- and middle-income countries, facilitating intervention strategies to promote appropriate antibiotic use and reduce antimicrobial resistance-related mortality.

Partners: Makerere University, Infectious Disease Research Centre, BioAmp, UTI-lizer
Researchers: CSG – Prof Catrin Moore, Dr Miriam Namtamu, Dr Arun Decano.
Makerere University – Prof Henry Kajumbula (PI), Dr Freddy Kitutu. IDRC – Dr James Kapisi (PI), Social scientists: Deborah Ekusai Sebatta, Tuheirwe Honest Kabaoba, Jonathan Enomut. Pharmacists/data analysts: Nakamanya Sharon Kitibwakye, Princess Edrine Kirabo, Solomon Gobba. Microbiology staff: Nalwanga Winnie, Masengere Agnes,Peter Amanya (MSc student)
Funder: The Wellcome Trust
Outputs



CURE
The Comprehensive Understanding of Disease and AI Research project
The CURE project addresses antimicrobial resistance by creating a comprehensive global data landscape mapping clinical, microbiological and antimicrobial use information. Using novel artificial intelligence tools, the project will describe the data landscape and begin to harmonise disparate datasets by outlining a common data platform that could be used. With SmartBiotic the team are harmonising data, using AI algorithms to enhance and fill gaps in currently existing clinical microbiology data which is informing evidence-based treatment guidelines. Through systematic reviews and collaboration with international experts, CURE will develop freely available tools that establish a scalable platform for AMR data, with future expansion planned across the One Health framework to support global efforts in reducing inappropriate antibiotic prescribing.
Partners: SmartBiotic, University of Leeds
Researchers: Dr Anne-Sophie Jung, Prof Ed Alonso, Dr Fredrick Mutisya, Louis Vezard, Taïoh Yokoyama, Dr Sana Boujaafar, Dr Mathieu Raad, Prof Catrin Moore
Funder: iiCON & UKRI
The Fleming Fund Fellowship in Eswatini
This Fellowship Scheme strengthens antimicrobial resistance workforce capacity by supporting professional development of practitioners within government institutions across Fleming Fund countries. Our team of mentors in CSG and RVS mentor fellows in specialised disciplines, they are in turn training their colleagues using their newly acquired skills. The programme focuses on advanced scientific and leadership development, bringing together human, animal health and environment professionals through a One Health approach. The team are currently supporting nine fellows in Eswatini, the scheme enhances capabilities in AMR diagnostic data collection, surveillance, data management and practical application to improve national AMR response. Two of the current Fellows recently ran a workshop on microbiology quality improvement in Piggs Peak, Eswatini which was supported by this work and the British High Commission in Eswatini.
Partners: Royal Veterinary College, University of London
Beneficiary Institutions: Eswatini Ministry of Health, Department of Veterinary Services – Central Veterinary Laboratory, Hlathikhulu Government Hospital, Good Shepherd Mission Hospital, Department of Water Affairs, Ministry of Agriculture Veterinary Public Health Division Food Hygiene Laboratory, Mbabane Government Hospital Laboratory
Mentors: Prof Catrin Moore, Prof Jodi Lindsay, Dr Yingfen Hsia, Dr Kurt Arden, Dr Sian Frosini, Dr Steven van Winden, Prof Anette Loeffler, Prof Tariq Sadiq, Dr Peter Crook, Dr Lauren Hookham, Dr Richard Booth, Dr Sally Baker
Mentees:
Andiswa Tenkhosi Dlamini – AMR Laboratory – Human Health
Bongiwe Elizabeth Ngozo – AMU-C Surveillance – Animal Health
Makhosazana Shongwe (Khosi) – AMR Laboratory – Environment
Precious Mumbi Chishimba – AMU-C Surveillance – Human Health
Nelisiwe Euphene Khumalo – AMU-C Surveillance – Animal Health
Melusi Welcome Mthembu – Antimicrobial Stewardship – Human Health
Nomcebo Fortunate Zondo – Antimicrobial Stewardship – Human Health
Bavukile Siphosethu Kunene – Antimicrobial Stewardship – Animal Health
Sifundo Patience Zwane – AMR Policy – Human Health
Alumni:
Mcolisi Buyisizwe Fakudze – AMR Laboratory – Animal Health
Zizwe M. Cindzi – AMU/C – Animal Health
Ronnie Mkoko – AMR Surveillance – Human Health
Sihle Gamma – AMU/C – Human Health
Funder: Department of Health & Social Care
Website: Fleming Fund Fellowships
Knocking out AMR
Prof Moore co-leads the Microbiology Society’s Knocking Out AMR project, a four-year initiative addressing the global antimicrobial resistance crisis. The project has convened 135 experts across One Health sectors to develop solutions in surveillance, diagnostics, vaccines and policy. Prof Moore led workshops in 2025 using an innovative complex systems approach. The initiative identified barriers and interventions, with findings published online. Prof Moore leads engagement activities including the AMR in Focus series, educational resources and collaboration with UK health agencies, representing the Society at high-level policy meetings including the 2024 UN General Assembly on AMR.
Website: Knocking Out Antimicrobial Resistance | Microbiology Society
The Fleming Fund Technical Assistance for Clinical Engagement Africa & Asia
Building on the ADILA initiative, the teams role in TACE is to enhance antimicrobial use data and quality across low- and middle-income countries in Africa and Asia. In partnership with IVI (Asia lead) and Fondation Mérieux (African lead), the project strengthens local surveillance and stewardship through training, technical support and through the use of data analysis tools. The TACE project promotes appropriate antibiotic prescribing using AWaRe Quality Indicators and a visualisation dashboard, enabling healthcare teams to integrate data into clinical care. The project empowers countries to address antimicrobial resistance through targeted, context-specific strategies based on local evidence.
Partners: University of Oxford, Global Point Prevalence Survey, International Vaccine Institute, Fondation Mérieux
Funder: Department of Health & Social Care
Websites: TACE AFRICA | TACE ASIA
ADILA
Antibiotic Data to Inform Local Action
The project aimed to develop open-access analyses and tools to guide national and local antibiotic prescribing policies. Key objectives included developing a methodology for deriving AWaRe-based national antibiotic targets, AWaRe quality indicators, methodology for collecting antibiotic prescribing data in primary healthcare, and for estimating expected antibiotic use in hospital and primary care based on clinical burden.
Partners: University of Antwerp, University of Oxford, Liverpool School of Tropical Medicine, Mahidol Oxford Tropical Research Unit,
Cambodia Oxford Medical Research Unit, National University of Singapore, Kenya Medical Research Institute
Researchers: Profs Michael Sharland and Catrin Moore at City St George’s, University of London, Dr Koen Pouwels at Nuffield Department of Primary Care Health Science and Dr Ben Cooper at Centre for Tropical Medicine and Global Health at the University of Oxford
Funders: The Wellcome Trust
Website: Antibiotic Policy Group – ADILA
Glossary
ADILA (Antibiotic Data to Inform Local Action)
A previous initiative focused on antimicrobial use surveillance that informed the development of the TACE project
AMR (Antimicrobial Resistance)
When bacteria, viruses, fungi and parasites change over time and no longer respond to medicines, making infections harder to treat
AMU (Antimicrobial Use)
The consumption and prescribing patterns of antimicrobial medicines, including antibiotics
AWaRe
Quality Indicators Assessment tools developed under ADILA to evaluate antibiotic prescribing practices. AWaRe classifies antibiotics as Access, Watch or Reserve based on their importance
CDRO (Community Drug Retail Outlet)
Pharmacies and drug shops in community settings where patients can obtain medicines
CURE (Comprehensive Understanding of Disease and AI Research)
A project using artificial intelligence to harmonise global antimicrobial resistance data
Fleming Fund
An international programme supporting low- and middle-income countries to strengthen antimicrobial resistance surveillance
Fondation Mérieux
An organisation leading consortium work on antimicrobial use in Africa
Genotypic/Genomic techniques
Laboratory methods that analyse the genetic material of bacteria to identify resistance genes
IVI (International Vaccine Institute)
An organisation leading consortium work on antimicrobial use in Asia
LMIC (Low- and Middle-Income Country)
Countries with lower economic development, often facing greater challenges in healthcare infrastructure
Multidrug resistance
When bacteria are resistant to multiple different antibiotics
One Health
An approach recognising that human, animal and environmental health are interconnected
OPD (Outpatient Clinic/Department)
Healthcare facilities where patients receive treatment without being admitted to hospital
Phenotypic techniques
Laboratory methods that test how bacteria respond to antibiotics in practice
Point Prevalence Survey (PPS)
A snapshot assessment of antibiotic use and prescribing practices at a specific point in time
Stewardship
Coordinated programmes to improve appropriate use of antimicrobials, including prescribing practices and treatment guidelines
TACE (Technical Assistance for Clinician Engagement)
A project enhancing antimicrobial use data quality and stewardship in Africa and Asia
UTI (Urinary Tract Infection)
An infection in any part of the urinary system, commonly treated with antibiotics
WHO-GLASS (World Health Organization Global Antimicrobial Resistance and Use Surveillance System)
WHO's global system for collecting and analysing antimicrobial resistance data to inform policy
Get in touch
For all enquiries relating to The Moore Group please contact us using this form: